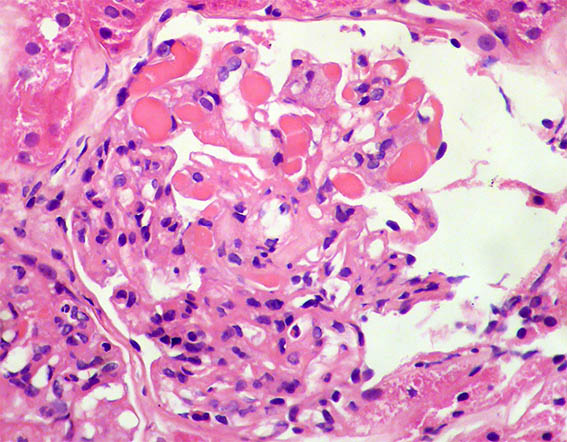

CASO
213 (noviembre de 2023)
Datos clínicos:
Una mujer de 62 años es evaluada por presentar eritema en ambas piernas, varias semanas de evolución. No hay antecedentes personales patológicos. En el exámen físico encuentran hipertensión arterial sistémica, edema de miembros inferiores, lesiones purpúricas en ambas piernas y fenómeno de Raynaud. En los paraclínicos el hemoleucograma es normal; creatinina sérica: 2,1 mg/dL, BUN: 39 mg/dL. ANAs, anti-DNA y ANCAs: negativos. C3: 82 mg/dL (84-180) y C4: 4,1 mg/dL (12-40). HIV y virus hepatotropos: negativos. En uroanálisis hay microhematuria, leucocitos: 5/CGA, proteinuria: 4,2 g/24 horas, con leve hipoalbuminemia.
Se hace biopsia renal. Observe las imágenes.

Figura 1. H&E, X400.
Figura 2. H&E, X400. Acúmulos hialinos intracapilares ("trombos hialinos").

Figura 3.
H&E, X200.

Figura 4. PAS, X400.

Figura 5. Tricrómico de Masson, X400.

Figura 6. Tricrómico de Masson, X400.

Figura 7. Plata-metenamina, X400.

Figura 8. Inmunofluorescencia directa para IgG, X400.

Figura 9. Inmunofluorescencia directa para cadenas ligeras kappa, X400.

Figura 10. Inmunofluorescencia directa para cadenas ligeras lambda, X400.

Figura 11. Microscopía electrónica, aumento original: X2.500. Hay edema endotelial y depósitos electron-densos subendoteliales.

Figura 12. Microscopía electrónica, aumento original: X4.000. Engrosamiento irregular de la MBG y depósitos electron-densos subendoteliales.

Figura 13. Microscopía electrónica, aumento original: X4.000. Depósitos electron-densos no organizados subendoteliales. Endotelio con pérdida de las fenestraciones por edema.

Figura 14. Microscopía electrónica, aumento original: X4.000.
En la inmunofluorescencia hay también positividad para C3 y, algo más débil, para C1q. IgA e IgM: Negativas.
¿Cuál es su diagnóstico?
Ver
diagnóstico y discusión
[Arriba]
|